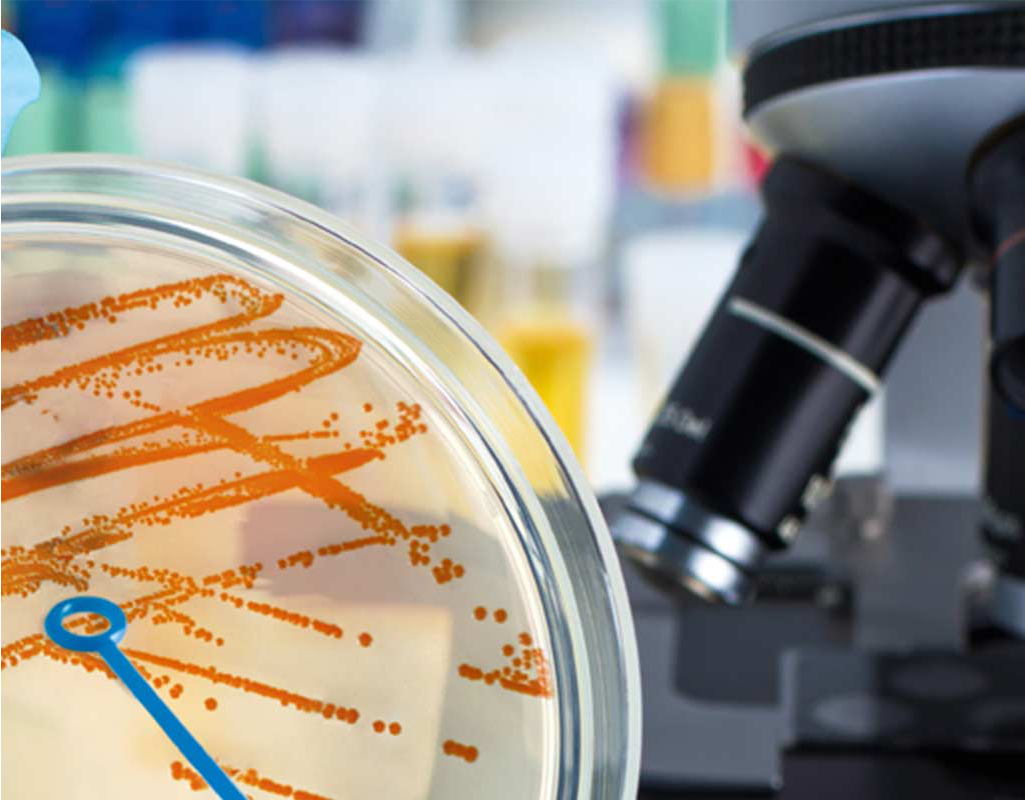

Play Video
Frequently Asked Questions
We offer an extensive array of diagnostic tests at Image Core Labs, including blood analysis, imaging services, and specialized screenings tailored to identify and manage a variety of health conditions effectively.
To schedule a health checkup, please call our office directly or conveniently book an appointment online through our user-friendly website for a hassle-free experience at Image Core Labs.
During your checkup at Image Core Labs, our expert team will perform thorough assessments, review your health history, and offer personalized recommendations tailored to your specific health needs and test results.